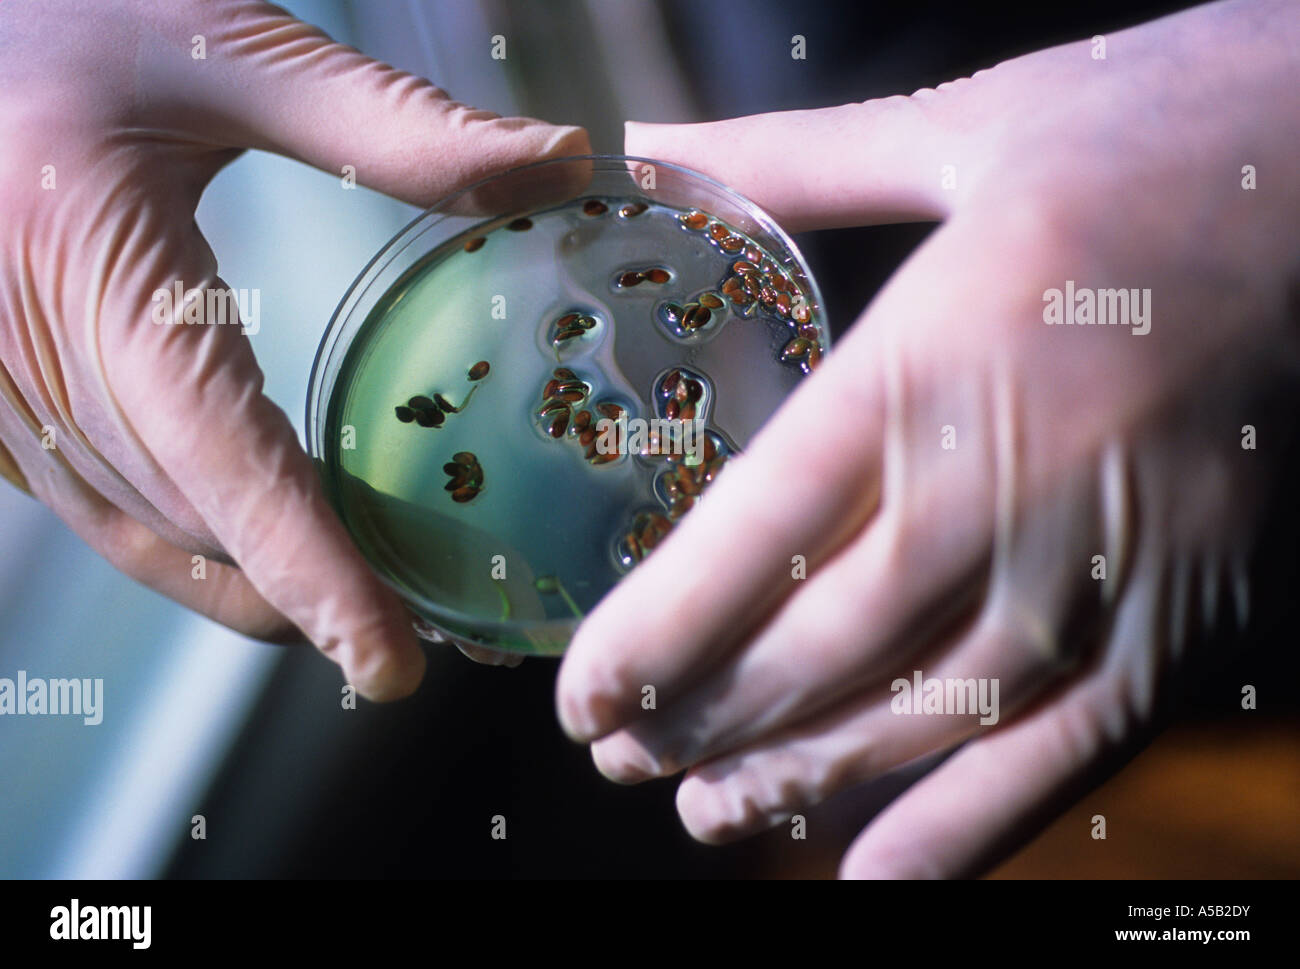
Ricerca scientifica. Assistenza sanitaria. Tecnico di laboratorio che indossa guanti in gomma con capsula di Petri. Igiene. Fornitore di assistenza sanitaria. Scienza medica USA Foto Stock
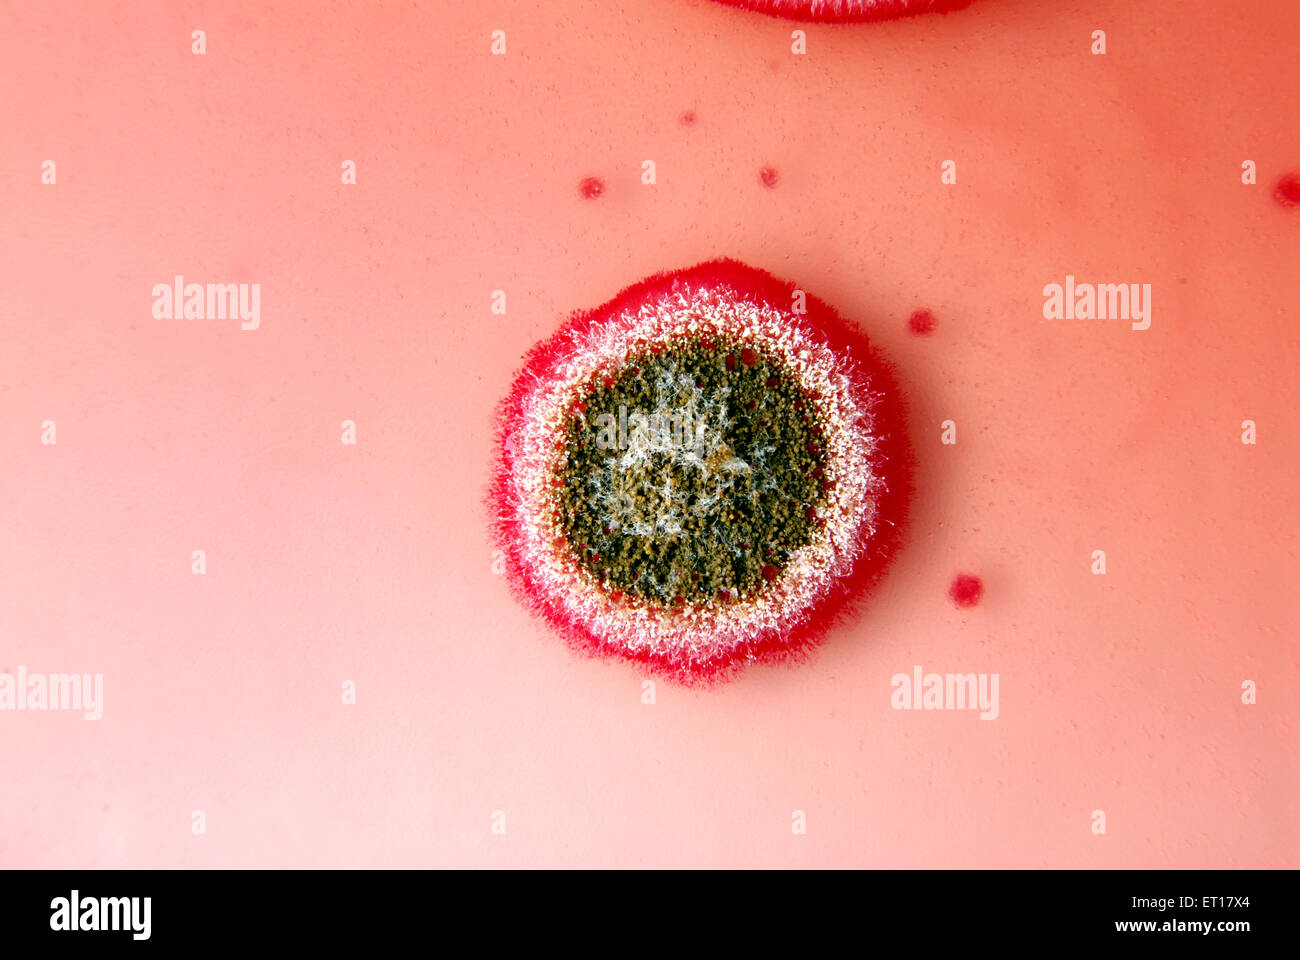
Ricerca scientifica colonie fungine semi di cotone su rosa bengala Chloramphenicol Agar Foto Stock

Ricerca scientifica Immagini Stock
(1,495,274)Filtri rapidi:
Ricerca scientifica Immagini Stock

RMB78B60–Ricerca scientifica biotech Genetics genoma lab la ricerca della sequenza di DNA di biologia molecolare pipetta tubo di campione

RFJXMX1B–Scienziato il pipettaggio di un campione in terreno contenente batteri per la ricerca scientifica in laboratorio

RF2A4BNJX–Ritratto di giovane donna che mantiene il tubo di prova oltre il bruciatore di gas mentre si lavora su una ricerca scientifica in laboratorio, spazio di copia

RF2EEAB38–Medico che lavora per analizzare campioni di sangue in laboratorio di ricerca scientifica. Concetto di chimica biologica ematologia HIV.

RF2BADG4N–Ai giovani scienziati guardando attraverso un microscopio in un laboratorio. Ai giovani scienziati di fare qualche ricerca.

RFBB27BT–Microscopio e di medici o di ricerca scientifica attrezzature in un ambiente di laboratorio

RFTBN67N–Laboratorio di analisi mediche tubo di prova in biologia chimica test di laboratorio. La ricerca e lo sviluppo scientifico e sanitario concetto sfondo

RF2BHR4RY–Scienziato che prepara una fiala per campioni per analisi utilizzando una pipetta in laboratorio utilizzata nella ricerca su DNA, medicina e farmacologia.

RMWHAY2W–Il Challenger piano come una ricerca scientifica nave. grafico originale dopo la conversione N M M. per permetterle di sondare le profondità, il Challenger pistole sono stati rimossi e i suoi longheroni ridotto per rendere disponibile una maggiore quantità di spazio. Laboratori, cabine extra e una speciale piattaforma di dragaggio sono stati installati. Il viaggio di Challenger, da Eric Linklater pagina 26-7. Il quinto dispositivo HMS Challenger (lanciato nel 1858) era un vapore assistita navale britannica, corvette in legno di 22306 tonnellate. Il capitano George narici era al comando con 243 funzionari, scienziati e equipaggio navale quando ha intrapreso la sua 68,890 miglio nautico (127,670 km)

RFG0NRJM–Ricerca scientifica nozione come un medico o scienziato ricercatore a camminare su una molecola di microscopiche come un medico-sanitari simbolo per biochimica con 3D'illustrazione degli elementi.

RF2RTD7J8–Microscopio da laboratorio professionale isolato: Ricerca scientifica e concetto di medicina

RFE8FXCJ–Ricerca scientifica Le idee come un concetto di biotecnologia con un laboratorio di un contagocce con liquido verde e una provetta di vetro a forma di bicchiere come un bulbo di luce come un simbolo di chimica discovery per nuovo sviluppo farmaceutico per combattere la malattia.

RF2BC330M–Le mani del medico con i guanti protettivi che tengono il COVID 19 Coronavirus testano il sangue facendo note statistiche. Test antivirus e concetto di ricerca. Focus su COVID-

RF2R6Y3CF–Un wildebeest blu (Connochaetes taurinus) dotato di un collare di tracciamento satellitare utilizzato per la ricerca scientifica, Sudafrica

RM2B8M09A–La nave di ricerca scientifica Alkor presso il GEOMAR Centre Kiel, Kiel, Schleswig-Holstein, Germania settentrionale, Europa centrale

RF2SACG2D–Un'illustrazione vettoriale di un laboratorio che conduce ricerche scientifiche, sperimentazioni e misurazioni su uno sfondo in stile cartone animato piatto

RF2ENA29H–Scienziato medico analizzando un test in computer per la competenza ospedaliera. Medico senior professionista che esamina l'evoluzione del vaccino utilizzando l'alta tecnologia per la ricerca scientifica, sviluppo del trattamento contro il covid19

RMCFJNEG–Ricerca scientifica piante che crescono con tarp presso la Cornell University di Ithaca, New York

RMHG79C1–New York City,NY NYC Manhattan,East River,F.D.R.,FDR Drive,Rockefeller University,Stavros Niarchos Foundation,Scientific research Complex,Under Constr
RMA5B2DY–Ricerca scientifica. Assistenza sanitaria. Tecnico di laboratorio che indossa guanti in gomma con capsula di Petri. Igiene. Fornitore di assistenza sanitaria. Scienza medica USA

RMWHAAE8–Un mondo ampia relazione sulla ricerca scientifica. Il primo programma in la serie televisiva della BBC che cosa è la vita? In cui lo scienziato guardava la cellula vivente e i misteri delle origini della vita sulla terra è stato introdotto da Proffessor Michael Swann e Raymond Baxter sulla BBC TV . Questa immagine mostra il famoso Upjohn modello di una cella all'interno dello studio. La cella era volato da Chicago e presentati in che cosa è la vita?

RF2D7NRAB–Atterraggio di ricerca scientifica. Studenti in camice bianco, ricercatori chimici medici con attrezzature di laboratorio. Pagina del vettore di Molecular ENGINEER. Illustrazione dell'esperimento di ricerca di scienziati di laboratorio

RF2RTD7JY–Microscopio da laboratorio professionale isolato: Ricerca scientifica e concetto di medicina

RM3A115T5–Vista aerea, Rheinisch-Westfälische Technische Hochschule Aachen, University RWTH Campus Melaten Nord, sede di ricerca scientifica, Campus-Boulevard,

RF2STTAPK–La manifestazione "Hands Off Our Healthcare" contro i tagli DEL DOGE alla ricerca scientifica e alla rimozione dei lavoratori federali nel Washington Square Park.

RMJ2T33K–Laboratorio di Daresbury Tower è una ricerca scientifica di base di laboratorio a Sci-Tech Daresbury scienza e innovazione campus Cheshire, Inghilterra, Warrington

RF2R5NYMT–Un wildebeest blu (Connochaetes taurinus) dotato di un collare di localizzazione satellitare utilizzato per la ricerca scientifica, Sudafrica

RM2B8KYN0–La nave di ricerca scientifica Alkor presso il GEOMAR Centre Kiel, Kiel, Schleswig-Holstein, Germania settentrionale, Europa centrale

RF2SACJ37–Un'illustrazione vettoriale di un laboratorio che conduce ricerche scientifiche, sperimentazioni e misurazioni su uno sfondo in stile cartone animato piatto

RF2B76YB9–Pompa dell'aria a doppia barrelata in cui due pesi in tubi separati sono fissati con una ruota dentata. Usato principalmente per la ricerca scientifica, e ha avuto Th

RMCFJNED–Ricerca scientifica piante che crescono con tarp presso la Cornell University di Ithaca, New York

RMPNE207–Londra Inghilterra,UK,Kensington,Natural History Museum,centro Darwin Cocoon,laboratorio di ricerca scientifica,collezioni di campioni zoologici conservati sto

RMT5AJ06–La RRS James Cook sul fiume Clyde è una ricerca scientifica nave DEL REGNO UNITO-basato Natural Environment Research Council (NERC)

RMWHAAFJ–Un mondo ampia relazione sulla ricerca scientifica. Il primo programma in la serie televisiva della BBC che cosa è la vita? In cui lo scienziato guardava la cellula vivente e i misteri delle origini della vita sulla terra è stato introdotto da Proffessor Michael Swann e Raymond Baxter sulla BBC TV . Questa immagine mostra il famoso Upjohn modello di una cella all'interno dello studio. La cella era volato da Chicago e presentati in che cosa è la vita? 1959

RF2H53E1R–Ricerca scientifica, scoperte. Logo per il settore sanitario, display interattivo HUD, schermo a sfioramento. Interventi sanitari, emergenza coronavirus, Covid-19
RF2C8TR6X–Scrivania da laboratorio medico con microscopio, icone e apparecchiature mediche: Ricerca scientifica e concetto tecnologico

RMC5GYAX–Fraunhofer Umsicht istituto per la ricerca scientifica. La ricerca di Redox-Flow batterie per lo stoccaggio di energia rinnovabile.

RM3A115TB–Vista aerea, Rheinisch-Westfälische Technische Hochschule Aachen, University RWTH Campus Melaten Süd, University Hospital, ricerca scientifica

RF2STTAT0–La manifestazione "Hands Off Our Healthcare" contro i tagli DEL DOGE alla ricerca scientifica e alla rimozione dei lavoratori federali nel Washington Square Park.

RF2SACRE4–Un'illustrazione vettoriale di un laboratorio che conduce ricerche scientifiche, sperimentazioni e misurazioni su uno sfondo in stile cartone animato piatto

RF2J1470B–Ragazzo ispanico che analizza la sostanza chimica in provetta mentre fa ricerca scientifica a casa

RMTWHKM6–Birla Auditorium edificio a Birla Institute di Ricerca Scientifica, Jaipur, Rajasthan, India

RMA68M6T–Le fiale di vetro e bicchieri usati in campo medico della ricerca scientifica lab laboratorio

RF2F3D5A7–Ricerca scientifica - mani di tecnici di laboratorio scientifici che pipettano in laboratorio di ricerca. Mano blu con guanti che preleva un campione di liquido in vetro.
RFPAXKHA–Microscopio scientifico icona. Illustrazione Vettoriale. Per la ricerca scientifica concetto in stile appartamento.

RF2H53MY3–Ricerca scientifica, scoperte. Logo per il settore sanitario, display interattivo HUD, schermo a sfioramento. Interventi sanitari, emergenza coronavirus, Covid-19. Viru

RMC5GY8P–Fraunhofer Umsicht istituto per la ricerca scientifica. La ricerca di Redox-Flow batterie per lo stoccaggio di energia rinnovabile.

RM3A115T4–Vista aerea, Rheinisch-Westfälische Technische Hochschule Aachen, University RWTH Campus Melaten Süd, University Hospital, ricerca scientifica

RF2STTA4H–La manifestazione "Hands Off Our Healthcare" contro i tagli DEL DOGE alla ricerca scientifica e alla rimozione dei lavoratori federali nel Washington Square Park.

RF2SACW5M–Un'illustrazione vettoriale di un laboratorio che conduce ricerche scientifiche, sperimentazioni e misurazioni su uno sfondo in stile cartone animato piatto

RF2D7JR94–Ricerca scientifica su piastre multipozzello per analisi del DNA con risultati genetici sullo sfondo

RF2Y5X318–Con un guanto, il campione viene inserito in una delle numerose provette in un ambiente di ricerca scientifica.

RMA68M8X–Le fiale di vetro e bicchieri usati in campo medico della ricerca scientifica lab laboratorio

RM2WK2Y94–Modello del satellite spaziale Ariel per la ricerca scientifica. Al di sopra dell'orizzonte terrestre alle stelle. Esperimenti su radiazioni elettromagnetiche e particelle cariche di energia

RF2YC7462–Eberly Minerals and Gems Gallery Washington DC // WASHINGTON DC - la mostra introduttiva alla Eberly Minerals and Gems Gallery delinea l'ambito della National Gem and Mineral Collection, che comprende oltre 300.000 esemplari raccolti in più di un secolo. Questo testo introduce i visitatori ai processi di formazione di minerali e gemme, evidenziando il duplice scopo della collezione sia per l'esposizione pubblica che per la ricerca scientifica.